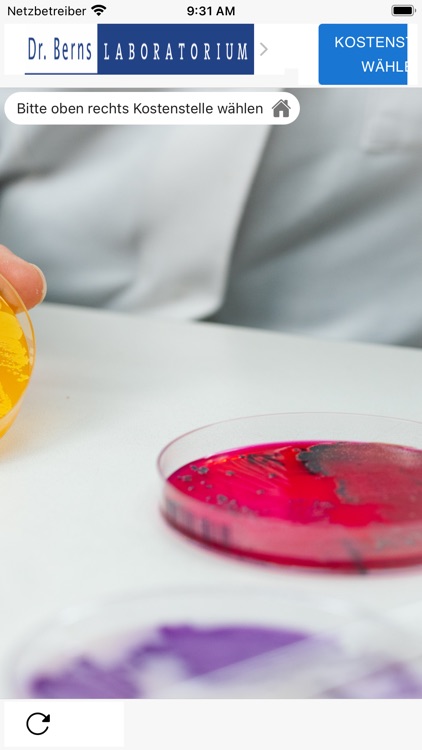
Dr. Berns Check

You are using an outdated browser. Please
upgrade your browser to improve your experience.
Dr Berns Check ermöglicht es Ihnen Prüfungen digital und einfach zu dokumentieren
Dr. Berns Check
by solufind

What is it about?
Dr Berns Check ermöglicht es Ihnen Prüfungen digital und einfach zu dokumentieren. Sie haben in der App Zugriff auf alle durch das Laboratorium Dr. Berns zur Verfügung gestellte Checklisten. Für die Nutzung der Anwendung wenden Sie sich gerne an Ihren Außendienstmitarbeiter.

App Store Description
Dr Berns Check ermöglicht es Ihnen Prüfungen digital und einfach zu dokumentieren. Sie haben in der App Zugriff auf alle durch das Laboratorium Dr. Berns zur Verfügung gestellte Checklisten. Für die Nutzung der Anwendung wenden Sie sich gerne an Ihren Außendienstmitarbeiter.
Disclaimer:
AppAdvice does not own this application and only provides images and links contained in the iTunes Search API, to help our users find the best apps to download. If you are the developer of this app and would like your information removed, please send a request to takedown@appadvice.com and your information will be removed.
AppAdvice does not own this application and only provides images and links contained in the iTunes Search API, to help our users find the best apps to download. If you are the developer of this app and would like your information removed, please send a request to takedown@appadvice.com and your information will be removed.